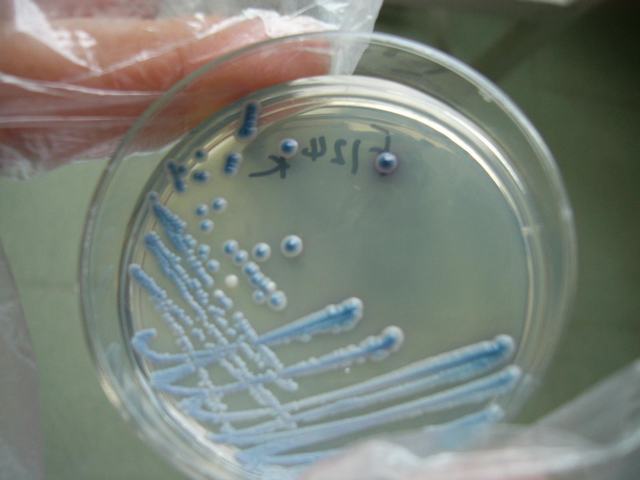
假丝酵母菌

假丝酵母菌显微镜

白假丝酵母菌
图片尺寸972x607
超治愈的的酵母菌显微镜下观察视频.
图片尺寸964x602
白假丝酵母菌落形态及显微观察 一般我们看到酵母都椭圆形的圆乎乎的
图片尺寸960x1280
外阴假丝酵母菌病的护理措施2013执业护士考试
图片尺寸535x468
2017-05-20 14:12:17ay12341楼白假丝酵母菌在实验室里像梅花一样,很
图片尺寸2336x4160
假丝酵母菌显微镜
图片尺寸504x330
显微镜下的酵母菌(暗场63x物镜 工业相机拍摄)
图片尺寸744x465
热带假丝酵母菌是什么
图片尺寸640x588
显微镜下的酵母菌
图片尺寸1279x720
白假丝酵母菌
图片尺寸853x645
p>热带假丝酵母(candida tropicalis)即 a target="_blank" href="
图片尺寸767x572
白色假丝酵母
图片尺寸480x383
假丝酵母菌孢子
图片尺寸404x320
含假菌丝的酵母细胞分支出芽
图片尺寸1200x763
第一节 白假丝酵母菌
图片尺寸555x367
美图欣赏——四种假丝酵母菌.
图片尺寸1280x1704
在显微镜下,酵母菌有哪些突出的特征区别于一般细菌?_你问我答网
图片尺寸580x387
假丝酵母菌
图片尺寸640x480
假丝酵母albican真菌
图片尺寸1200x987
显微镜下的酵母菌(图片来源于网络)
图片尺寸599x493